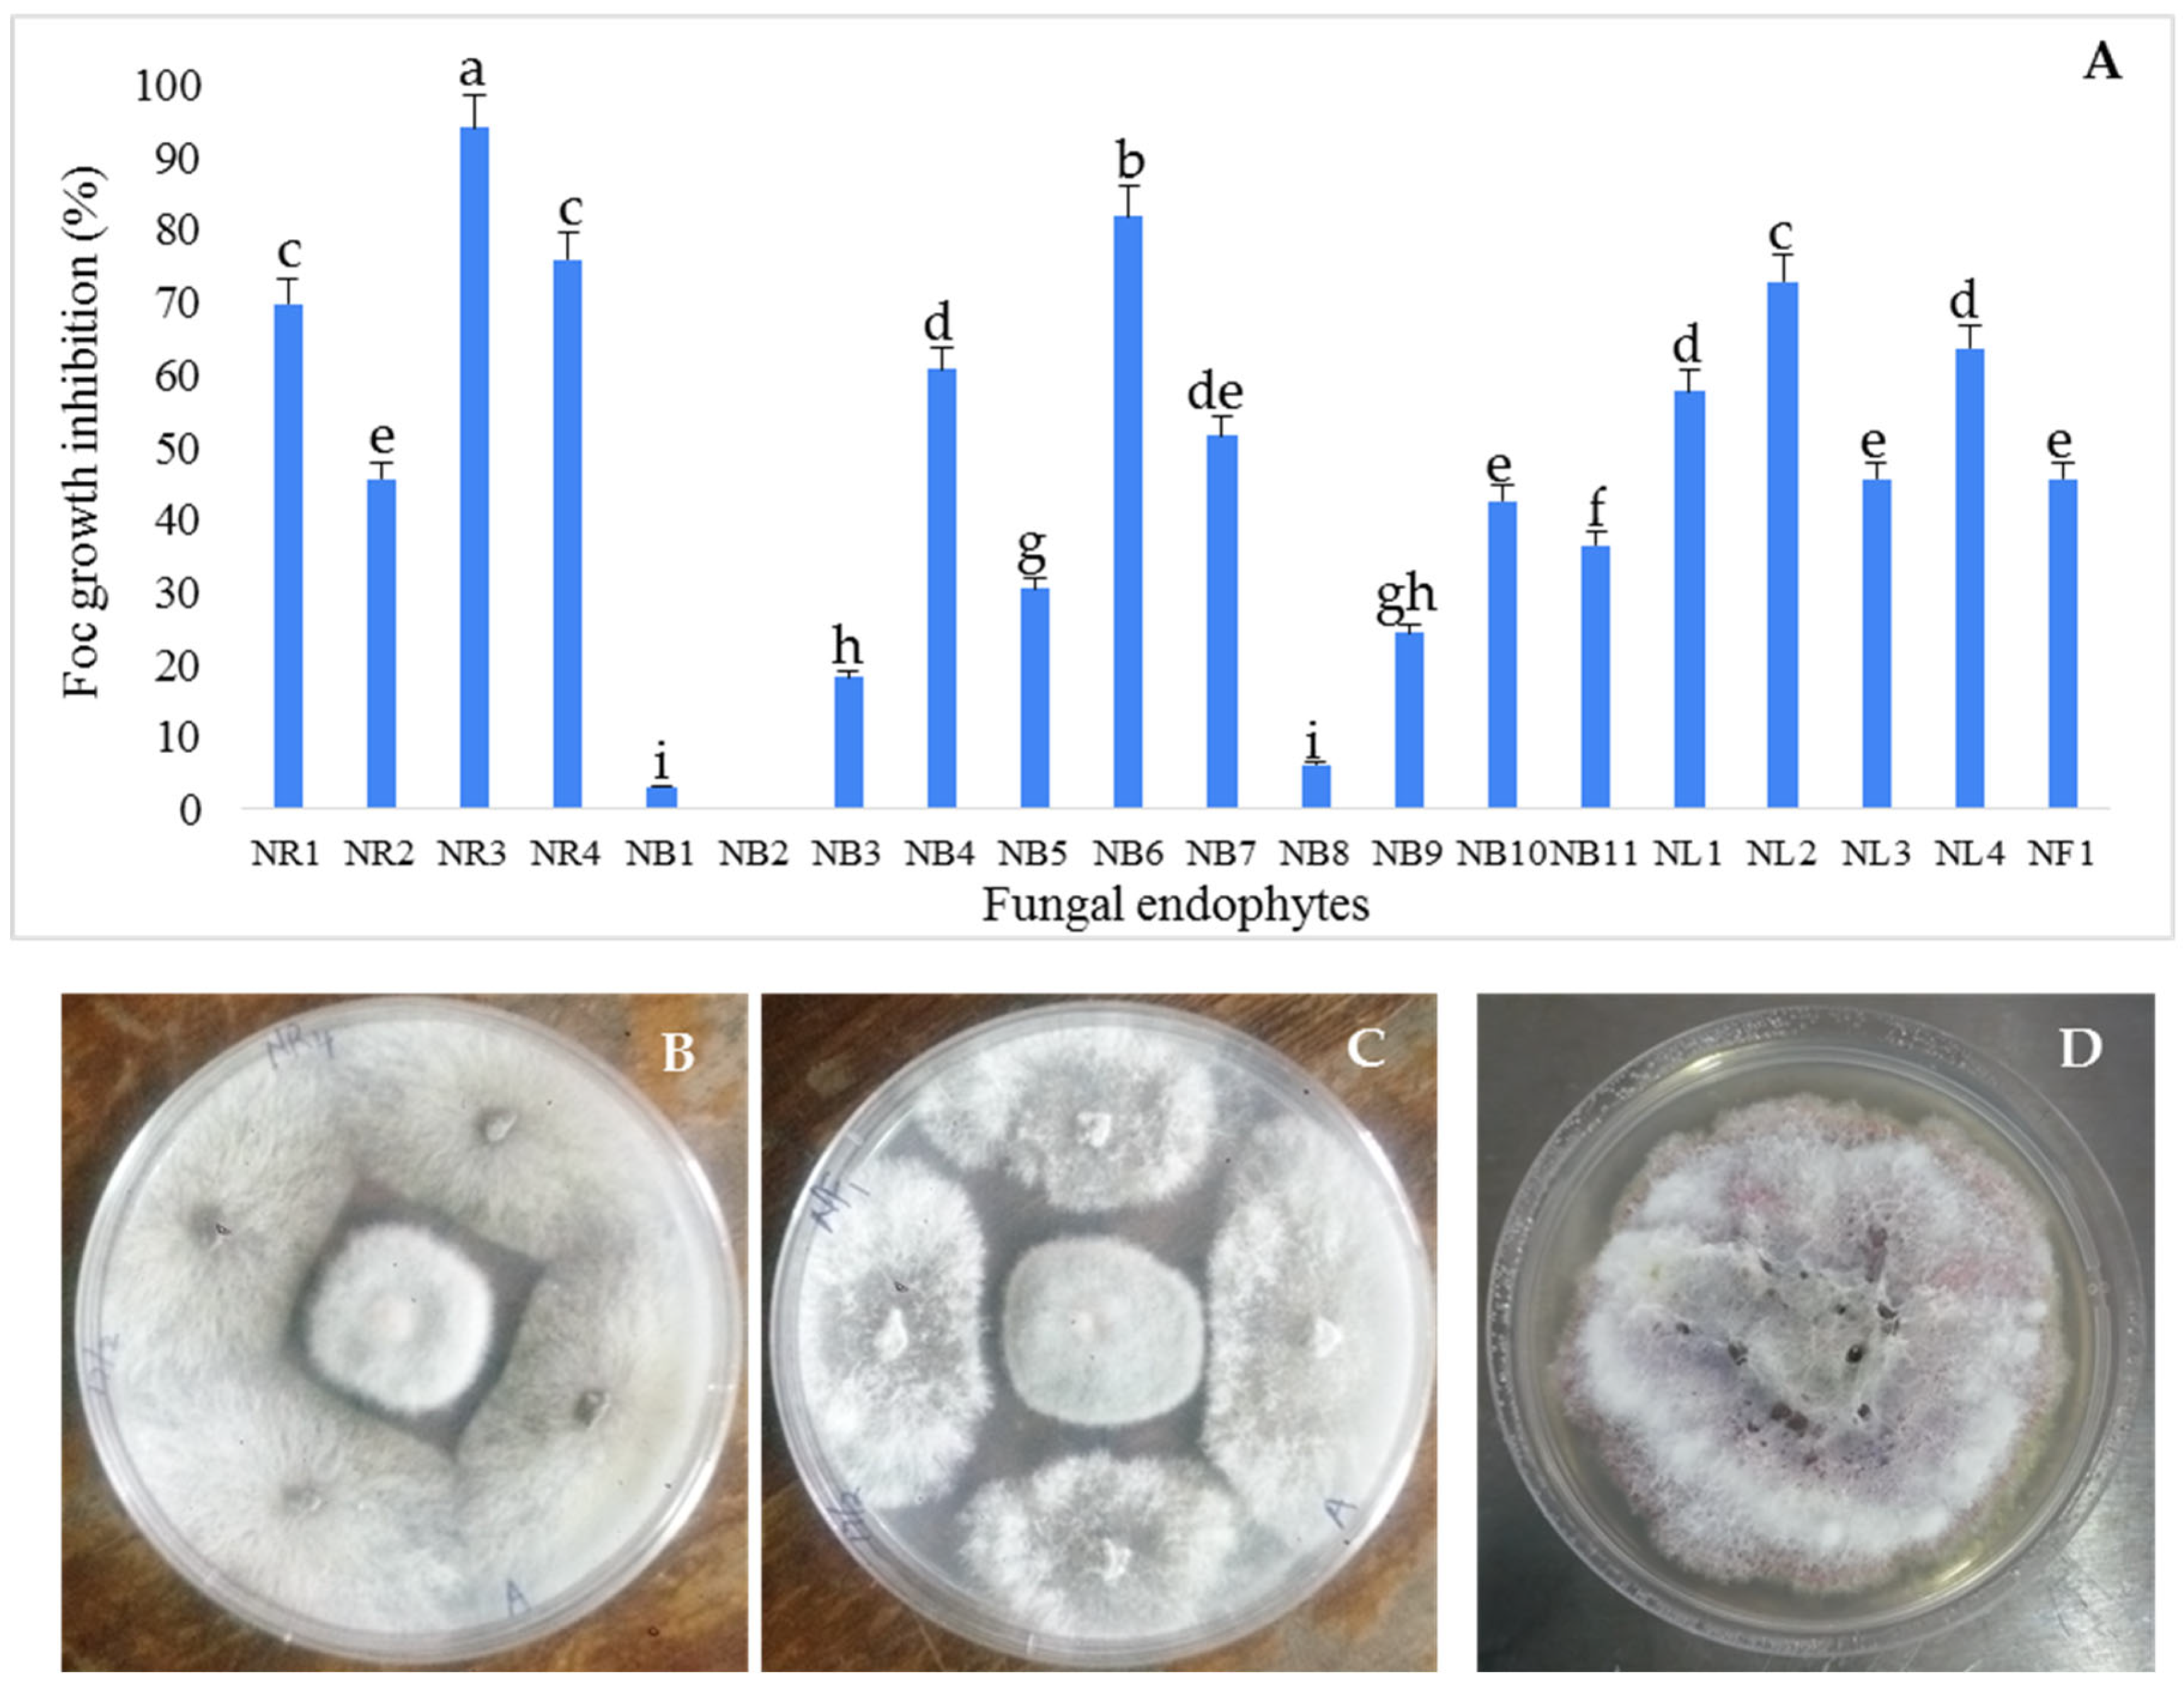
Microbiolres 14 00143 g002

Fungal Endophytes of Moringa (Moringa oleifera L.), Neem (Azadirachta indica) and Lavender (Lavandula angustifolia) and Their Biological Control of Fusarium Wilt of Banana
Abstract
1. Introduction
2. Materials and Methods
2.1. Collection of Plant Material
2.2. Isolation of Fungal Endophytes
2.3. Dual-Culture Assay to Identify Fungal Endophytes with Antifungal Activity (Pre-Screening)
2.4. Pathogenicity Test of Fungal Endophytes to Banana Cultivar Grand Naine
2.5. Morphological Characterization of the Antagonistic Endophytic Fungi
2.6. Molecular Identification of Antagonistic Fungal Endophytes
2.7. Effect of Culture Filtrates of Antagonistic Endophytic Fungi on In Vitro Growth of Foc TR4
2.8. Analysis of Activities of Endo- and Exo-glucanases
2.8.1. Determination of Endo-β-1,3-Glucanase Activity
2.8.2. Determination of Exo-β-1,3-Glucanase Activity
2.9. Evaluation of Antifungal Activities of Selected Endophytic Fungi against Foc in the Greenhouse
3. Results
3.1. Isolation and Antifungal Activity Testing of the Endophytic Fungi Isolates
3.2. Pathogenicity of Selected Fungal Endophytes Banana Cultivar Grand Naine
3.3. Identification of Selected Fungal Endophytes with Antifungal Activity
3.4. Antifungal Activity of Culture Filtrates of Selected Fungal Endophytes against Foc TR4
3.5. Production of Glucanases by the Antagonistic Endophytic Fungi
3.6. Evaluation of Selected Fungal Endophytes on Improving Plant Resistance against Foc TR4
4. Discussion
5. Conclusions
Supplementary Materials
Author Contributions
Funding
Institutional Review Board Statement
Informed Consent Statement
Data Availability Statement
Acknowledgments
Conflicts of Interest
References
- Pua, E.C.; Davey, M.R. Banana. In Transgenic Crops V; Springer: Berlin/Heidelberg, Germany, 2007; Volume 60, pp. 3–34. [Google Scholar]
- Dash, P.K.; Rai, R. Translating the Banana Genome to Delineate Stress Resistance, Dwarfing, Parthenocarpy and Mechanisms of Fruit Ripening. Front. Plant Sci. 2016, 7, 1543. [Google Scholar] [CrossRef] [PubMed]
- FAOSTAT. FAO Statistical Database. 2021. Available online: http://www.fao.org/ (accessed on 30 May 2022).
- Drenth, A.; Kema, G. The Vulnerability of Bananas to Globally Emerging Disease Threats. Phytopathol 2021, 111, 2146–2161. [Google Scholar] [CrossRef] [PubMed]
- Dale, J.; James, A.; Paul, J.; Khanna, H.; Smith, M.; Peraza-Echeverria, S.; Garcia-Bastidas, F.; Kema, G.; Waterhouse, P.; Mengersen, K.; et al. Transgenic Cavendish bananas with resistance to Fusarium wilt tropical race 4. Nat. Commun. 2017, 8, 1496. [Google Scholar] [CrossRef] [PubMed]
- Pegg, K.G.; Moore, N.Y.; Bentley, S. Fusarium wilt of banana in Australia: A review. Austral. J. Agric. Res. 1996, 47, 637–650. [Google Scholar] [CrossRef]
- Nguyen, T.V.; Tran-Nguyen, L.T.T.; Wright, C.L.; Trevorrow, P.; Grice, K. Evaluation of the efficacy of commercial disinfectants against Fusarium oxysporum f. sp. cubense race 1 and tropical race 4 propagules. Plant Dis. 2019, 103, 721–728. [Google Scholar]
- Souza, I.F.; Napoleão, T.H.; de Sena, K.X.; Paiva, P.M.; de Araújo, J.M.; Coelho, L.C. Endophytic microorganisms in leaves of Moringa oleifera collected in three localities at Pernambuco State, Northeastern Brazil. Brit. Microbiol. Res. J. 2016, 13, 1. [Google Scholar] [CrossRef]
- Chen, A.; Sun, J.; Matthews, A.; Armas-Egas, L.; Chen, N.; Hamill, S.; Mintoff, S.; Tran-Nguyen, L.T.T.; Batley, J.; Aitken, E.A.B. Assessing variations in host resistance to Fusarium oxysporum f sp. cubense Race 4 in Musa species, with a Focus. on the subtropical race 4. Front. Microbiol. 2019, 10, 1062. [Google Scholar] [CrossRef]
- Ploetz, R.C. Fusarium Wilt of Banana. Phytopathology 2015, 105, 1512–1521. [Google Scholar] [CrossRef]
- Dong, X.; Xiong, Y.; Ling, N.; Shen, Q.; Guo, S. Fusaric acid accelerates the senescence of leaf in banana when infected by Fusarium. World J. Microbiol. Biotechnol. 2014, 30, 1399–1408. [Google Scholar] [CrossRef]
- Dita, M.; Barquero, M.; Heck, D.; Mizubuti, E.S.G.; Staver, C.P. Fusarium wilt of banana: Current knowledge on epidemiology and research needs toward sustainable disease management. Front. Plant Sci. 2018, 9, 1468. [Google Scholar] [CrossRef]
- Gang, G.; Bizun, W.; Weihong, M.; Xiaofen, L.; Xiaolin, Y.; Chaohua, Z.; Jianhong, M.; Huicai, Z. Biocontrol of Fusarium wilt of banana: Key influence factors and strategies. Afr. J. Microbiol. Res. 2013, 7, 4835–4843. [Google Scholar]
- Pegg, K.G.; Coates, L.M.; O’Neill, W.T.; Turner, D.W. The Epidemiology of Fusarium Wilt of Banana. Front. Plant Sci. 2019, 10, 1395. [Google Scholar] [CrossRef] [PubMed]
- Jamil, F.N.; Tang, C.N.; Saidi, N.B.; Lai, K.S.; Baharum, N.A. Fusarium wilt in banana: Epidemics and management strategies. In Horticultural Crops; Baimey, H.K., Hamamouch, N., Kolombia, Y.A., Eds.; IntechOpen: London, UK, 2019; pp. 117–142. [Google Scholar]
- Siamak, S.B.; Zheng, S. Banana Fusarium wilt (Fusarium oxysporum f. sp. cubense) control and resistance, in the context of developing wilt-resistant bananas within sustainable production systems. Hortic. Plant J. 2018, 4, 208–218. [Google Scholar] [CrossRef]
- Cannon, S.; Kay, W.; Kilaru, S.; Schuster, M.; Gurr, S.J.; Steinberg, G. Multi-site fungicides suppress banana Panama disease, caused by Fusarium oxysporum f. sp. cubense Tropical Race 4. PLoS Pathog. 2022, 18, e1010860. [Google Scholar] [CrossRef] [PubMed]
- Bubici, G.; Kaushal, M.; Prigigallo, M.I.; Gómez-Lama Cabanás, C.; Mercado-Blanco, J. Biological Control Agents Against Fusarium Wilt of Banana. Front. Microbiol. 2019, 10, 616. [Google Scholar] [CrossRef] [PubMed]
- Lv, N.; Tao, C.; Ou, Y.; Wang, J.; Deng, X.; Liu, H.; Shen, Z.; Li, R.; Shen, Q. Root-associated antagonistic Pseudomonas spp. contributes to soil suppressiveness against banana Fusarium wilt disease of banana. Microbiol. Spect. 2023, 11, e0352522. [Google Scholar] [CrossRef] [PubMed]
- Tao, C.; Wang, Z.; Liu, S.; Lv, N.; Deng, X.; Xiong, W.; Shen, Z.; Zhang, N.; Geisen, S.; Li, R.; et al. Additive fungal interactions drive biocontrol of Fusarium wilt disease. New Phytol. 2023, 238, 1198–1214. [Google Scholar] [CrossRef]
- Xiang, D.; Yang, X.; Liu, B.; Chu, Y.; Liu, S.; Li, C. Bio-priming of banana tissue culture plantlets with endophytic Bacillus velezensis EB1 to improve Fusarium wilt resistance. Front. Microbiol. 2023, 14, 1146331. [Google Scholar] [CrossRef]
- Zhu, Z.; Wu, G.; Deng, R.; Hu, X.; Tan, H.; Chen, Y.; Tian, Z.; Li, J. Spatiotemporal biocontrol and rhizosphere microbiome analysis of Fusarium wilt of banana. Commun. Biol. 2023, 6, 27. [Google Scholar] [CrossRef]
- Jamiołkowska, A. Natural compounds as elicitors of plant resistance against diseases and new biocontrol strategies. Agronomy 2020, 10, 173. [Google Scholar] [CrossRef]
- Jaber, L.R.; Alananbeh, K.M. Fungal entomopathogens as endophytes reduce several species of Fusarium causing crown and root rot in sweet pepper (Capsicum annuum L.). Biol. Control 2018, 126, 117–126. [Google Scholar] [CrossRef]
- Onsare, J.G.; Kaur, H.; Arora, D.S. Antimicrobial activity of Moringa oleifera from different locations against some human pathogens. Acad. J. Med. Plants 2013, 1, 80–91. [Google Scholar]
- Ke, Y.; Chen, Z.; Ma, J.B.; Huang, X.M.; Zeng, S.R. Studies of isolation of endophytic fungi from Moringa sp. and antibiotic active substance produced by the Aspergillus sp. ly14. J.-Hunan Agric. Univ. 2006, 32, 521. [Google Scholar]
- Zhao, J.H.; Zhang, Y.L.; Wang, L.W.; Wang, J.Y.; Zhang, C.L. Bioactive secondary metabolites from Nigrospora sp. LLGLM003, an endophytic fungus of the medicinal plant Moringa oleifera Lam. World J. Microbiol. Biotechnol. 2012, 28, 2107–2112. [Google Scholar] [CrossRef]
- Nicoletti, M.; Murugan, K. Neem the tree of 21st century. Pharmacologyonline 2013, 3, 115–121. [Google Scholar]
- Kumar, D.; Rahal, A.; Malik, K.J. Neem extract. In Nutraceuticals. Efficacy, Safety and Toxicity; Ramesh, C., Ed.; Gupta: Chennai, India, 2016; pp. 585–597. [Google Scholar]
- Wylie, M.R.; and Merrell, D.S. The Antimicrobial Potential of the Neem Tree Azadirachta indica. Front. Pharmacol. 2022, 13, 891535. [Google Scholar] [CrossRef] [PubMed]
- Hossain, M.A.; Al-Toubi, W.A.S.; Weli, A.M.; Al-Riyami, Q.A.; Al-Sabahi, J.N. Identification and characterization of chemical compounds indifferent crude extracts from leaves of Omani neem. J. Taibah Uni. Sci. 2013, 7, 181–188. [Google Scholar] [CrossRef]
- Robu, S.; Aprotosoaie, A.C.; Miron, A.; Cioancǎ, O.; Stǎnescu, U.; Hǎncianu, M. In vitro antioxidant activity of ethanolic extracts from some Lavandula species cultivated in Romania. Farmacia 2012, 60, 394–401. [Google Scholar]
- Turgut, A.C.; Emen, F.M.; Canbay, H.S.; Demirdöğen, R.E.; Çam, N.; Kılıç, D.; Yeşilkaynak, T. Chemical characterization of Lavandula angustifolia Mill. which is a phytocosmetic species and investigation of its antimicrobial effect in cosmetic products. J. Turk. Chem. Soc. Sect. A Chem. 2016, 4, 283–298. [Google Scholar] [CrossRef]
- Zuzarte, M.; Gonçalves, M.J.; Cavaleiro, C.; Cruz, M.T.; Benzarti, A.; Marongiu, B.; Maxia, A.; Piras, A.; Salgueiro, L. Antifungal and anti-inflammatory potential of Lavandula stoechas and Thymus herba-barona essential oils. Ind. Crops Prod. 2013, 44, 97–103. [Google Scholar] [CrossRef]
- Dita, M.A.; Waalwijk, C.; Buddenhagen, I.W.; Souza, M.T., Jr.; Kema, G.H.J. A molecular diagnostic for tropical race 4 of the banana fusarium wilt pathogen. Plant Pathol. 2010, 59, 348–357. [Google Scholar] [CrossRef]
- Ellis, M.B. Dematiaceous Hyphomycetes; Commonwealth Mycological Institute: London, UK, 1971; 608p. [Google Scholar]
- Gilman, J. A manual of soil fungi. Soil. Sci. 1957, 84, 183. [Google Scholar] [CrossRef]
- Doyle, J.J. Isolation of plant DNA from fresh tissue. Focus 1990, 12, 13–15. [Google Scholar]
- Miller, G.L. Use of Dinitrosalicylic Acid Reagent for Determination of Reducing Sugar. Anal. Chem. 1959, 31, 426–428. [Google Scholar] [CrossRef]
- Mak, C.; Mohamed, A.A.; Liew, K.W.; Ho, Y.W. Early screening technique for Fusarium wilt resistance in banana micropropagated plants. In Banana Improvement: Cellular, Molecular Biology, and Induced Mutations; Swennen, R., Jain, M.S., Eds.; Science Publishers, Inc.: Enfield, NH, USA, 2004; pp. 219–227. [Google Scholar]
- Yadav, S.; Goswami, P.; Mathur, J. Evaluation of fungicidal efficacy of Moringa oleifera Lam. leaf extract against Fusarium wilt in wheat. J. Nat. Pestic. Res. 2023, 4, 100034. [Google Scholar] [CrossRef]
- Ahmadu, T.; Ahmad, K.; Ismail, S.I.; Rashed, O.; Asib, N.; Omar, D. Antifungal efficacy of Moringa oleifera leaf and seed extracts against Botrytis cinerea causing gray mold disease of tomato (Solanum lycopersicum L.). Braz. J. Biol. 2021, 81, 1007–1022. [Google Scholar] [CrossRef]
- Hassanein, N.M.; Abou Zeid, M.A.; Youssef, K.A.; Mahmoud, D.A. Efficacy of Leaf Extracts of Neem (Azadirachta indica) and Chinaberry (Melia azedrach) Against Early Blight and Wilt Diseases of Tomato. Aust. J. Basic. Appl. Sci. 2008, 2, 763–772. [Google Scholar]
- Vidal, A.; Parada, R.; Mendoza, L.; Cotoras, M. Endophytic Fungi Isolated from Plants Growing in Central Andean Precordillera of Chile with Antifungal Activity against Botrytis cinerea. J. Fungi 2020, 6, 149. [Google Scholar] [CrossRef]
- Pakdaman, B.S.; Goltapeh, E.M.; Soltani, B.M. Toward the quantification of confrontation (dual culture) test: A case study on the biological control of Pythium aphanidermatum with Trichoderma asperelloides. J. Biofertil. Biopestic. 2013, 4, 1000137. [Google Scholar] [CrossRef]
- Bae, H.; Roberts, D.P.; Lim, H.S. Endophytic Trichoderma isolates from tropical environments delay disease onset and induce resistance against Phytophthora capsici in hot pepper using multiple mechanisms. Mol. Plant Microbe Interact. 2011, 24, 336–351. [Google Scholar] [CrossRef]
- Saxena, A.; Raghuwanshi, R.; Singh, H.B. Elevation of defense network in chilli against Colletotrichum capsici by phyllospheric Trichoderma strain. J. Plant Growth Regul. 2016, 35, 377–389. [Google Scholar] [CrossRef]
- Thambugala, K.M.; Daranagama, D.A.; Phillips, A.J.L.; Kannangara, S.D.; Promputtha, I. Fungi vs. fungi in biocontrol: An overview of fungal antagonists applied against fungal plant pathogens. Front. Cell Infect. Microbiol. 2020, 10, 604923. [Google Scholar] [CrossRef]
- Hamzah, T.N.T.; Lee, S.Y.; Hidayat, A.; Terhem, R.; Faridah-Hanum, I.; Mohamed, R. Diversity and Characterization of Endophytic Fungi Isolated from the Tropical Mangrove Species, Rhizophora mucronata, and Identification of Potential Antagonists Against the Soil-Borne Fungus, Fusarium solani. Front. Microbiol. 2018, 9, 1707. [Google Scholar] [CrossRef]
- Liu, J.; Yu, Y.; Cai, Z.; Bartlam, M.; Wang, Y. Comparison of ITS and 18S rDNA for estimating fungal diversity using PCR-DGGE. World J. Microbiol. Biotechnol. 2015, 31, 1387–1395. [Google Scholar] [CrossRef] [PubMed]
- Salvatore, M.M.; Alves, A.; Andolfi, A. Secondary metabolites produced by Neofusicoccum species associated with plants: A Review. Agriculture 2021, 11, 149. [Google Scholar] [CrossRef]
- Fravel, D.; Olivain, C.; Alabouvette, C. Fusarium oxysporum and its biocontrol. New Phytol. 2003, 157, 493–502. [Google Scholar] [CrossRef] [PubMed]
- Michielse, C.B.; Rep, M. Pathogen profile update: Fusarium oxysporum. Mol. Plant Pathol. 2009, 10, 311–324. [Google Scholar] [CrossRef]
- Lei, L.-R.; Gong, L.-Q.; Jin, M.-Y.; Wang, R.; Liu, R.; Gao, J.; Liu, M.-D.; Huang, L.; Wang, G.-Z.; Wang, D.; et al. Research advances in the structures and biological activities of secondary metabolites from Talaromyces. Front. Microbiol. 2022, 13, 984801. [Google Scholar] [CrossRef]
- Li, F.; Lin, S.; Zhang, S.; Pan, L.; Chai, C.; Su, J.C.; Zhang, Y. Modified fusicoccane-type diterpenoids from Alternaria brassicicola. J. Nat. Prod. 2020, 83, 1931–1938. [Google Scholar] [CrossRef]
- Tian, L.L.; Ren, H.; Xi, J.M.; Fang, J.; Zhang, J.Z.; Wu, Q.X. Diverse anti-inflammation and anti-cancer polyketides isolated from the endophytic fungi Alternaria sp. MG1. Fitoter. 2021, 153, 105000. [Google Scholar] [CrossRef]
- Shi, Z.Z.; Miao, F.P.; Fang, S.T.; Liu, X.H.; Yin, X.L.; Ji, N.Y. Sesteralterin and tricycloalterfurenes A–D: Terpenes with rarely occurring frameworks from the marine-alga-epiphytic fungus Alternaria alternata k21-1. J. Nat. Prod. 2017, 80, 2524–2529. [Google Scholar] [CrossRef] [PubMed]
- Eze, P.M.; Nnanna, J.C.; Okezie, U.; Buzugbe, H.S.; Abba, C.C.; Chukwunwejim, C.R.; Okoye, F.B.C.; Esimone, C.O. Screening of metabolites from endophytic fungi of some Nigerian medicinal plants for antimicrobial activities. EuroBiotechnol. J. 2019, 3, 10–18. [Google Scholar] [CrossRef]
- Mwanga, Z.; Mvungi, E.; Tibuhwa, D. Antimicrobial Activities of Endophytic Fungi Secondary Metabolites from Moringa oleifera (Lam). Tanzan. J. Sci. 2019, 45, 463–476. [Google Scholar]
- Xu, K.; Li, X.-Q.; Zhao, D.-L.; Zhang, P. Antifungal Secondary Metabolites Produced by the Fungal Endophytes: Chemical Diversity and Potential Use in the Development of Biopesticides. Front. Microbiol. 2021, 12, 689527. [Google Scholar] [CrossRef] [PubMed]
- Kaur, N.; Arora, D.S. Prospecting the antimicrobial and antibiofilm potential of Chaetomium globosum an endophytic fungus from Moringa oleifera. AMB Expr. 2020, 10, 206. [Google Scholar] [CrossRef]
- Kaur, N.; Arora, D.S.; Kalia, N.; Kaur, M. Bioactive potential of endophytic fungus Chaetomium globosum and GC–MS analysis of its responsible components. Sci. Rep. 2020, 10, 18792. [Google Scholar] [CrossRef] [PubMed]
- Patil, M.G.; Pagare, J.; Patil, S.N.; Sidhu, A.K. Extracellular enzymatic activities of endophytic fungi isolated from various medicinal plants. Int. J. Curr. Microbiol. App. Sci. 2015, 4, 1035–1042. [Google Scholar]
- Xiong, T.; Xie, S.; Xue, Y.; Bai, R.; Feng, J.; Guan, Z.; Liao, X.; Cai, Y. Isolation of endophytic fungi of phenolic acids in lavender and the identification of its products. J. Food Sci. Biotechnol. 2018, 37, 250–255. [Google Scholar]
- Liu, F.; Cai, X.; Yang, H.; Xia, X.; Guo, Z.; Yuan, J.; Li, M.; She, Z.; Lin, Y. The bioactive metabolites of the mangrove endophytic fungus Talaromyces sp. ZH-154 isolated from Kandelia candel (L.) druce. Planta Med. 2010, 76, 185–189. [Google Scholar] [CrossRef]
- Yang, H.; Li, F.; Ji, N. Alkaloids from an algicolous strain of Talaromyces sp. Chin. J. Oceanol. Limnol. 2016, 34, 367–371. [Google Scholar] [CrossRef]
- Root-Bernstein, M.; Valenzuela, R.; Huerta, M.; Armesto, J.; Jaksic, F. Acacia caven nurses endemic sclerophyllous trees along a successional pathway from silvopastoral savanna to forest. Ecosphere 2017, 8, e01667. [Google Scholar] [CrossRef]
- Prieto, A.; de Eugenio, L.; Mendez-Liter, J.A.; Nieto-Dominguez, M.; Murgiondo, C.; Barriuso, J.; Bejarano-Munoz, L.; Martinez, M.J. Fungal glycosyl hydrolases for sustainable plant biomass valorization: Talaromyces amestolkiae as a model fungus. Int. Microbiol. 2021, 24, 545–558. [Google Scholar] [CrossRef] [PubMed]
- Fesel, P.H.; Zuccaro, A. β-glucan: Crucial component of the fungal cell wall and elusive MAMP in plants. Fungal Genet. Biol. 2016, 90, 53–60. [Google Scholar] [CrossRef] [PubMed]
- Schoffelmeer, E.A.M.; Klis, F.M.; Sietsma, J.H.; Cornelissen, B.J.C. The Cell Wall of Fusarium oxysporum. Fungal Genet. Biol. 1999, 27, 275–282. [Google Scholar] [CrossRef] [PubMed]
- Kavino, M.; Kumar, N.; Damodaran, T.; Harish, S.; Saravanakumar, D. Biochemical markers as a useful tool for the early identification of Fusarium oxysporum f. sp. cubense, race 1 resistance banana clones. Arch. Phytopathol. Pflanzenschutz. 2009, 42, 1069–1078. [Google Scholar] [CrossRef]
- Migheli, Q.; Friard, O.; Del Tedesco, D.; Musso, M.R.; Gullino, M.L. Stability of transformed antagonistic Fusarium oxysporum strains in vitro and in soil microcosms. Mol. Ecol. 1996, 5, 641–649. [Google Scholar] [CrossRef]
- Yamaguchi, T.; Yamada, A.; Hong, N.; Ogawa, T.; Ishii, T.; Shibuya, N. Differences in the Recognition of Glucan Elicitor Signals between Rice and Soybean: β-Glucan Fragments from the Rice Blast Disease Fungus Pyricularia Oryzae That Elicit Phytoalexin Biosynthesis in Suspension-Cultured Rice Cells. Plant Cell 2000, 12, 817–826. [Google Scholar]
- Wanke, A.; Malisic, M.; Wawra, S.; Zuccaro, A. Unraveling the Sugar Code: The Role of Microbial Extracellular Glycans in Plant-Microbe Interactions. J. Exp. Bot. 2021, 72, 15–35. [Google Scholar] [CrossRef]
- Wink, M. Functions and Biotechnology of Plant Secondary Metabolites. In Annual Plant Reviews, 2nd ed.; Blackwell Publishing Ltd.: Hoboken, NJ, USA, 2010; Volume 39. [Google Scholar]
- Smith, L.J.; Smith, M.K.; Tree, D.; O’Keefe, D.; Galea, V.J. Development of a small-plant bioassay to assess banana grown from tissue culture for consistent infection by Fusarium oxysporum f. Sp. Cubense. Austral. Plant Pathol. 2008, 37, 171–179. [Google Scholar] [CrossRef]
- García-Bastidas, F.A.; Van der Veen, A.J.T.; Nakasato-Tagami, G.; Meijer, H.J.G.; Arango-Isaza, R.E.; Kema, G.H.J. An Improved Phenotyping Protocol for Panama Disease in Banana. Front. Plant Sci. 2019, 10, 1006. [Google Scholar] [CrossRef]
- Babu, R.M.; Sajeena, A.; Seetharaman, K.; Vidhyasekaran, P.; Rangasamy, P.; Som Prakash, M.; Raja, A.S.; Biji, K.R. Host range of Alternaria alternata—A potential fungal biocontrol agents for water hyacinth in India. Crop Prot. 2002, 21, 1083–1085. [Google Scholar] [CrossRef]
- Nel, B.; Steinberg, C.; Labuschagne, N.; Viljoen, A. The potential of non-pathogenic Fusarium oxysporum and other biological control organisms for suppressing Fusarium wilt of banana. Plant Pathol. 2006, 55, 217–223. [Google Scholar] [CrossRef]
- Tian, Y.; Zhao, Y.; Fu, X.; Yu, C.; Gao, K.; Liu, H. Isolation and identification of Talaromyces SP. strain Q2 and its biocontrol mechanisms involved in the control of Fusarium wilt. Front. Microbiol. 2021, 12, 724842. [Google Scholar] [CrossRef] [PubMed]
- Motlagh, M.R.S.; Mohammadian, S. Identification of non-pathogenic fungi of rice and the evaluation of their effect on biological control of Bipolaris oryzae, the causal agent of rice brown spot disease in vitro. J. Agric. For. 2017, 63, 291. [Google Scholar]

| Rhizome Discoloration Index | Description of the Symptom |
|---|---|
| 1 | No discoloration of the tissue in the stellar region of the rhizome and the surrounding region |
| 2 | No discoloration of the tissue in the stellar region of the rhizome. Discoloration of the junctions of root and rhizome |
| 3 | Trace up to 5% of the stellar region discolored |
| 4 | 6 to 20% of the stellar region discolored |
| 5 | 21 to 50% of the stellar region discolored |
| 6 | More than 50% of the stellar region discolored |
| 7 | The entire rhizome stele discolored |
| 8 | The plant is completely dead |
| Isolate | Colony Size (mm) | Colony Appearance | Colony Structure | Growth Rate (Fast/Slow) | Colony Color on PDA | Hyphae | Conidiophores | Conidia |
|---|---|---|---|---|---|---|---|---|
| LB1 | 62 | Cottony | Circular flat | Fast growing | Greyish white | Septate, branched | Septate, simple, smooth-walled | Septate, fusiform, ellipsoidal, with ovoid base |
| LR1 | 47.5 | Cottony | Circular raised | Fast growing | White | Septate, non-branched | Septate with short and thick phialides | Septate, slightly curved, thick, ovoid, tapered and slightly hooked |
| MB7 | 70.5 | Woolly | Circular flat | Fast growing | White | Septate, filamentous | Septate, branched | Have transverse and longitudinal septations, appear singly -Ovoid, darkly pigmented, muriform and smooth |
| MB14 | 67.5 | Floccose | Circular raised | Slow growing | White, red in the center | Septate, branched, hyaline | Septate, solitary, simple or branched, smooth-walled | Smooth-walled, single-celled, ellipsoidal |
| NB6 | 73.5 | Cottony | Elliptical raised | Fast growing | Grey, black in the center | Septate, branched | Septate, elongated and simple, non-branched. | Short-chained, elliptical, beaked, septate transversely |
| NR3 | 73.5 | Cottony | Circular raised | Fast growing | Greyish white | Septate, elongated | Septate, elongated | Ovoid, septate, muriform, smooth, long-chained, short-beaked |
| Isolate Code | GenBank Accession Number of the Isolate | Closest Match of the ITS Sequence (Accession Number) | Query Cover | Maximum Identity (%) | Identity of the Isolate (Closest Related Species) |
|---|---|---|---|---|---|
| LB1 | MW578725 | Neofusicoccum parvum (OP077308) | 100% | 100% | Neofusicoccum parvum |
| LR1 | MW578726 | Fusarium oxysporum (KJ623246) | 100% | 100% | Fusarium oxysporum |
| MB7 | MW578727 | Alternaria alternata (MK675999) | 100% | 100% | Alternaria alternata |
| MB14 | MW578728 | Talaromyces amestolkiae (MN192157) | 100% | 99.71% | Talaromyces amestolkiae |
| NB6 | MW578729 | Alternaria tenuissima (MW136777) | 100% | 100% | Alternaria tenuissima |
| NR3 | MW578730 | Alternaria alternata (MN822520) | 100% | 100% | Alternaria alternata |
| Treatment | Plant Height (cm) | Number of Leaves |
|---|---|---|
| NI-CTRL | 27.11 ± 1.23 c | 9.2 ± 0.51 c |
| LB1 | 31.91 ± 1.42 bc | 15.5 ± 1.11 a |
| LR1 | 31.87 ± 1.31 bc | 12.43 ± 0.32 b |
| MB7 | 34.61 ± 1.77 b | 11.34 ± 1.43 b |
| MB14 | 34.98 ± 1.12 b | 12.52 ± 0.81 b |
| NB6 | 33.79 ± 1.9 b | 12.44 ± 0.73 b |
| NR3 | 38.51 ± 1.61 a | 16.12 ± 0.77 a |
| Foc TR4 | 21.32 ± 1.73 d | 7.48 ± 0.33 d |
| LB1 + Foc TR4 | 32.32 ±1.47b c | 14.22 ± 0.43 ab |
| LR1 + Foc TR4 | 31.53 ± 1.92 bc | 13.16 ± 1.12 b |
| MB7 + Foc TR4 | 34.92 ± 1.11 b | 12.64 ± 0.37 b |
| MB14 + Foc TR4 | 33.96 ± 1.59 b | 12.42 ± 0.94 b |
| NB6 + Foc TR4 | 34.29 ± 2.1 b | 13.32 ± 0.27 b |
| NR3 + Foc TR4 | 38.12 ± 0.87 a | 15.56 ± 0.61 a |
Disclaimer/Publisher’s Note: The statements, opinions and data contained in all publications are solely those of the individual author(s) and contributor(s) and not of MDPI and/or the editor(s). MDPI and/or the editor(s) disclaim responsibility for any injury to people or property resulting from any ideas, methods, instructions or products referred to in the content. |
© 2023 by the authors. Licensee MDPI, Basel, Switzerland. This article is an open access article distributed under the terms and conditions of the Creative Commons Attribution (CC BY) license (https://creativecommons.org/licenses/by/4.0/).
Share and Cite
Nthuku, B.M.; Kahariri, E.W.; Kinyua, J.K.; Nyaboga, E.N. Fungal Endophytes of Moringa (Moringa oleifera L.), Neem (Azadirachta indica) and Lavender (Lavandula angustifolia) and Their Biological Control of Fusarium Wilt of Banana. Microbiol. Res. 2023, 14, 2113-2132. https://doi.org/10.3390/microbiolres14040143
Nthuku BM, Kahariri EW, Kinyua JK, Nyaboga EN. Fungal Endophytes of Moringa (Moringa oleifera L.), Neem (Azadirachta indica) and Lavender (Lavandula angustifolia) and Their Biological Control of Fusarium Wilt of Banana. Microbiology Research. 2023; 14(4):2113-2132. https://doi.org/10.3390/microbiolres14040143
Chicago/Turabian StyleNthuku, Bonface M., Esther W. Kahariri, Johnson K. Kinyua, and Evans N. Nyaboga. 2023. "Fungal Endophytes of Moringa (Moringa oleifera L.), Neem (Azadirachta indica) and Lavender (Lavandula angustifolia) and Their Biological Control of Fusarium Wilt of Banana" Microbiology Research 14, no. 4: 2113-2132. https://doi.org/10.3390/microbiolres14040143
APA StyleNthuku, B. M., Kahariri, E. W., Kinyua, J. K., & Nyaboga, E. N. (2023). Fungal Endophytes of Moringa (Moringa oleifera L.), Neem (Azadirachta indica) and Lavender (Lavandula angustifolia) and Their Biological Control of Fusarium Wilt of Banana. Microbiology Research, 14(4), 2113-2132. https://doi.org/10.3390/microbiolres14040143

